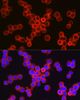
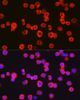

CD11b (ITGAM) Rabbit Polyclonal Antibody
Frequently bought together (1)
Other products for "ITGAM"
Specifications
| Product Data | |
| Applications | ICC/IF, IHC, WB |
| Recommended Dilution | WB,1:500 - 1:2000 IHC,1:50 - 1:200 IF,1:50 - 1:200 |
| Reactivities | Human, Mouse, Rat |
| Modifications | Unmodified |
| Host | Rabbit |
| Isotype | IgG |
| Clonality | Polyclonal |
| Immunogen | Recombinant fusion protein containing a sequence corresponding to amino acids 20-330 of human CD11b/ITGAM (NP_001139280.1). |
| Formulation | Buffer: PBS with 0.09% Sodium azide,50% glycerol,pH7.3. |
| Concentration | lot specific |
| Purification | Affinity purification |
| Conjugation | Unconjugated |
| Storage | Store at -20℃. Avoid freeze / thaw cycles. |
| Stability | Shelf life: one year from despatch. |
| Predicted Protein Size | 127kDa |
| Gene Name | integrin subunit alpha M |
| Database Link | |
| Background | This gene encodes the integrin alpha M chain. Integrins are heterodimeric integral membrane proteins composed of an alpha chain and a beta chain. This I-domain containing alpha integrin combines with the beta 2 chain (ITGB2) to form a leukocyte-specific integrin referred to as macrophage receptor 1 ('Mac-1'), or inactivated-C3b (iC3b) receptor 3 ('CR3'). The alpha M beta 2 integrin is important in the adherence of neutrophils and monocytes to stimulated endothelium, and also in the phagocytosis of complement coated particles. Multiple transcript variants encoding different isoforms have been found for this gene. |
| Synonyms | CD11B; CR3A; MAC-1; MAC1A; MGC117044; MO1A; SLEB6 |
| Reference Data | |
Documents
| Product Manuals |
| FAQs |
| SDS |
{0} Product Review(s)
0 Product Review(s)
Submit review
Be the first one to submit a review
Product Citations
*Delivery time may vary from web posted schedule. Occasional delays may occur due to unforeseen
complexities in the preparation of your product. International customers may expect an additional 1-2 weeks
in shipping.






























































































































































































































































 Germany
Germany
 Japan
Japan
 United Kingdom
United Kingdom
 China
China